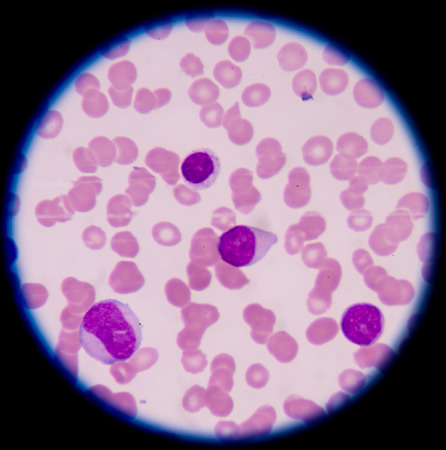
A blood smear is often used as a follow-up test to abnormal results on a complete blood count (CBC) to evaluate the different types of blood cells.の写真素材

写真素材 - A blood smear is often used as a follow-up test to abnormal results on a complete blood count (CBC) to evaluate the different types of blood cells.
作品情報
A blood smear is often used as a follow-up test to abnormal results on a complete blood count (CBC) to evaluate the different types of blood cells.
- ID:40856925
- 作品種別:写真
- 作者名:toeytoey
キーワード
- abnormal
- acute
- anemia
- antigen
- bactericidal
- band
- basophil
- beta
- biology
- blast
- blood
- bone
- cell
- cytoplasm
- decrease
- disease
- eosinophil
- granulation
- health
- hematology
- immune
- increase
- infection
- laboratory
- leukemia
- leukocyte
- lobed
- lymphocyte
- macrocyte
- marrow
- medical
- medicine
- microbiology
- microcyte
- microscope
- monocyte
- myeloblast
- myeloblastic
- myelocyte
- neutrophil
- normal
- nucleus
- organism
- pathology
- phagocytes
- platelet
- pmn
- promyelocyte
- red
- response
- segmented
- slide
- smear
- system
- thalassemia
- thalassemias
- toxic
- white
- metamyelocyte
類似作品
Medical laborat...
Test tubes with...
glass and syrin...
Scientist holdi...
Glass dropper a...
A drop of blood...
Woman dropping ...
Neutrophil show...
Young doctor wo...
Blood smear wit...
Glass dropper a...
Blood film
Blood film
Drops of blood ...
glass with bloo...
doctor will put...
drop of blood o...
Malaria blood p...
Polycythemia ve...
Young doctor wo...
Manual dissecti...
Immature white...
Glass dropper a...
Rows of microsc...
Blood sampling ...
complete blood ...
Blood smear for...
Blood group tes...
Blood slide
Glass dropper a...
Malaria blood p...
Medical laborat...
Close up shot o...
The study paras...
Scientist holdi...
nucleated red c...
Medicine - Huma...
Brush of red na...
microscope lens...
Scientist dripp...
blood smear is ...
Picture of acut...
Close-up detail...
Doctor working ...
in Slide blood ...
Wax blurs in wa...
lab technician ...
Blood group tes...
blood in glass ...